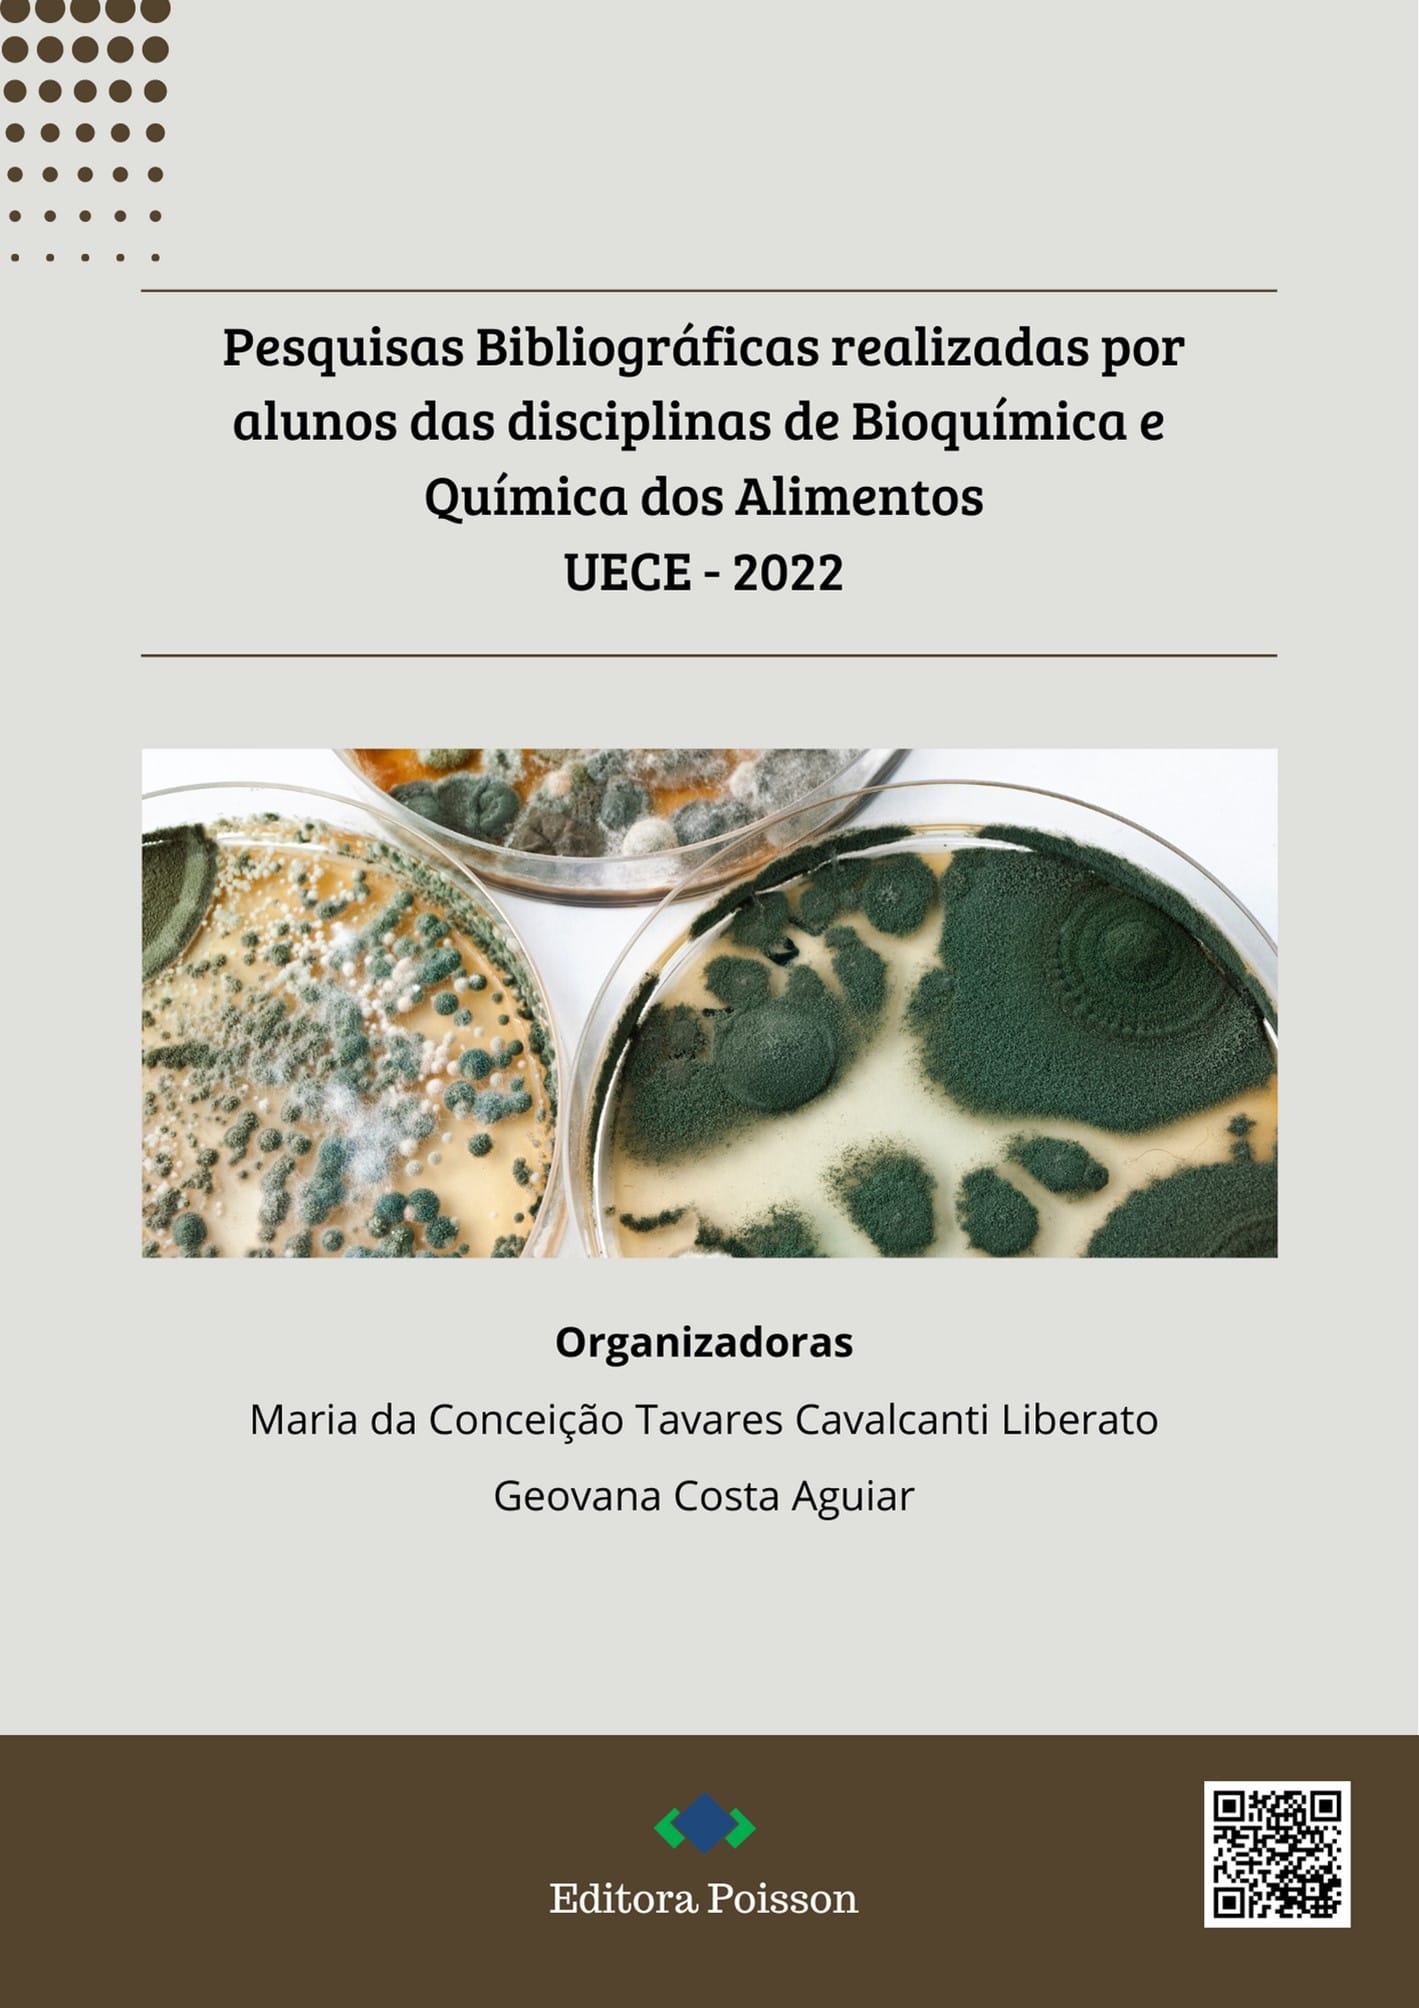

Pesquisas Bibliográficas Realizadas por Alunos das Disciplinas de Bioquímica e Química dos Alimentos UECE – 2022
ISBN
DOI
Descrição
Ler Online
Preencha o formulário abaixo e receberá no seu email o link para baixar o livro.
Conteúdo
Capítulo 1: A degradação enzimática do plástico em ácido tereftálico e a transformação desse em MOF e sua importância ambiental
Célia Cristina Moraes Ferreira, Charlyson de Souza Galvão, João Vitor de Oliveira Freitas, Maria da Conceição Tavares Cavalcanti Liberato
DOI: 10.36229/978-65-5866-172-6.CAP.01
Capítulo 2: Obesidade e sua relação com aumento de casos de síndrome metabólica durante a pandemia de COVID-19
Guilherme Sousa Castro, Mauricio da Silveira Gomes, Paulo Lincoln da Silva Oliveira, Maria da Conceição Tavares Cavalcanti Liberato
DOI: 10.36229/978-65-5866-172-6.CAP.02
Capítulo 3: Proteases
Anna Raquel Silva de Castro, Glória Stefany Carias Santos, Maria Eduarda Camelo Veras, Maria da Conceição Tavares Cavalcanti Liberato
DOI: 10.36229/978-65-5866-172-6.CAP.03
Capítulo 4: Hipertensão arterial
Sara Ingrid Caetano Gomes Barbosa, Sarah de Sousa Sales, Maria da Conceição Tavares Cavalcanti Liberato
DOI: 10.36229/978-65-5866-172-6.CAP.04
Capítulo 5: Diferente, seja hoje: causas, sintomas, diagnóstico, tratamento e prevenção da hipertensão. Saúde e bem-estar
Giovanna Hellen Sousa, Iaci Torres Paiva, Natália Maria Rocha de Araújo, Maria da Conceição Tavares Cavalcanti Liberato
DOI: 10.36229/978-65-5866-172-6.CAP.05
Capítulo 6: Resistência à insulina
Yanna Julie da Silva Freitas, Maria da Conceição Tavares Cavalcanti Liberato
DOI: 10.36229/978-65-5866-172-6.CAP.06
Capítulo 7: Tratamento de diabetes
Éven de Lima Paiva, Maria da Conceição Tavares Cavalcanti Liberato
DOI: 10.36229/978-65-5866-172-6.CAP.07
Capítulo 8: Principais temas acerca da enzima lipase: uma revisão bibliográfica
Cecília Lara Oliveira Lima, Maria da Conceição Tavares Cavalcanti Liberato
DOI: 10.36229/978-65-5866-172-6.CAP.08
Capítulo 9: Quantificação de fenóis, flavonoides e análise fitoquímicas da espécie Anacardium occidentale L. (cajueiro)
Gustavo Henrique Gomes Teixeira, Keylla Feitosa Oliveira, Maria da Conceição Tavares Cavalcanti Liberato
DOI: 10.36229/978-65-5866-172-6.CAP.09
Capítulo 10: Hemocromatose: Entendendo a doença e análise de caso
Antônia Cristina Fortes Santos, Ricardo Venicius Silva de Oliveira, Maria da Conceição Tavares Cavalcanti Liberato
DOI: 10.36229/978-65-5866-172-6.CAP.10
Capítulo 11: Estudo sobre diabetes tipo 2: Revisão bibliográfica
Jordana Lima Braga, Leonard Euler Rodrigues Nogueira, Luana Rodrigues da Silva, Maria da Conceição Tavares Cavalcanti Liberato
DOI: 10.36229/978-65-5866-172-6.CAP.11
Capítulo 12: Uma revisão sobre congelamento de frutas e hortaliças
Brena Kelly Soares de Castro, Maria da Conceição Tavares Cavalcanti Liberato
DOI: 10.36229/978-65-5866-172-6.CAP.12
Capítulo 13: Mel da abelha melipona subnitida
Luma Teixeira Cavalcante, Maria da Conceição Tavares Cavalcanti Liberato
DOI: 10.36229/978-65-5866-172-6.CAP.13
Capítulo 14: Açúcar: A verdade não tão doce
Tifany Costa de Oliveira, Maria da Conceição Tavares Cavalcanti Liberato
DOI: 10.36229/978-65-5866-172-6.CAP.14
Capítulo 15: Ingredientes e processos de produção da cerveja tradicional: Um breve resumo bibliográfico do assunto
Thiago Bricio Pinheiro Sandre, Maria da Conceição Tavares Cavalcanti Liberato
DOI: 10.36229/978-65-5866-172-6.CAP.15
Capítulo 16: Fatores da pré-colheita influenciam na qualidade final dos produtos
Maria Luana Norjosa Cordeiro, Maria da Conceição Tavares Cavalcanti Liberato
DOI: 10.36229/978-65-5866-172-6.CAP.16
Capítulo 17: Aspectos fisiológicos do desenvolvimento de frutas e hortaliças
Jamylle Kévina Rodrigues Moreira, Maria da Conceição Tavares Cavalcanti Liberato
DOI: 10.36229/978-65-5866-172-6.CAP.17
Capítulo 18: Aspectos e critérios das cervejas artesanais
Paulo Henrique Ferreira de Brito, Maria da Conceição Tavares Cavalcanti Liberato
DOI: 10.36229/978-65-5866-172-6.CAP.18
Capítulo 19: Mel da abelha apis mellífera
Yanna Julie da Silva Freitas., Maria da Conceição Tavares Cavalcanti Liberato
DOI: 10.36229/978-65-5866-172-6.CAP.19
Capítulo 20: Microrganismos
Glória Stefany Carias Santos, Maria Eduarda Camelo Veras, Maria da Conceição Tavares Cavalcanti Liberato
DOI: 10.36229/978-65-5866-172-6.CAP.20
Capítulo 21: Pigmentos e corantes
Letícia de Fátima Paz Mendes, Maria da Conceição Tavares Cavalcanti Liberato
DOI: 10.36229/978-65-5866-172-6.CAP.21
Capítulo 22: Segurança no consumo da proteína isolada da soja
Rebecca Gomes Lopes, Maria da Conceição Tavares Cavalcanti Liberato
DOI: 10.36229/978-65-5866-172-6.CAP.22
Capítulo 23: Qualidade de frutas e hortaliças: Perdas pós colheita
Lucas Nóbrega Vasconcelos, Maria da Conceição Tavares Cavalcanti Liberato
DOI: 10.36229/978-65-5866-172-6.CAP.23
Capítulo 24: Colesterol: entendendo a química por trás da molécula
Vinícios da Silva Simões, Maria da Conceição Tavares Cavalcanti Liberato
DOI: 10.36229/978-65-5866-172-6.CAP.24
Capítulo 25: Vitaminas presentes nas frutas e hortaliças: Estudo bibliográfico
Iane Santos de Sousa, Jordana Lima Braga, Paulo Davy de Freitas Benedito, Maria da Conceição Tavares Cavalcanti Liberato
DOI: 10.36229/978-65-5866-172-6.CAP.25
Capítulo 26: Perfil nutricional da soja
Ingrid Alves Melo, Maria da Conceição Tavares Cavalcanti Liberato
DOI: 10.36229/978-65-5866-172-6.CAP.26
Capítulo 27: Corantes e pigmentos: revisão
Daniele Cristine De Lima Andrade, Maria da Conceição Tavares Cavalcanti Liberato
DOI: 10.36229/978-65-5866-172-6.CAP.27
Capítulo 28: Carotenóides
Misael Torres Martins, Maria da Conceição Tavares Cavalcanti Liberato
DOI: 10.36229/978-65-5866-172-6.CAP.28
Capítulo 29: Deterioração de lipídios e rancidez de gorduras
Raimundo Gilberto de Moura Filho, Maria da Conceição Tavares Cavalcanti Liberato
DOI: 10.36229/978-65-5866-172-6.CAP.29
Capítulo 30: Cerveja artesanal com polpa de maracujá
Francisca Tainara Gonzaga Machoca, Maria da Conceição Tavares Cavalcanti Liberato
DOI: 10.36229/978-65-5866-172-6.CAP.30
Capítulo 31: Cervejas tradicionais
Maria Diná Nascimento Lima, Maria da Conceição Tavares Cavalcanti Liberato
DOI: 10.36229/978-65-5866-172-6.CAP.31
Capítulo 32: Consequências biológicas da oxidação de lipídios
Sara Ingrid Caetano Gomes Barbosa, Sarah de Sousa Sales, Maria da Conceição Tavares Cavalcanti Liberato
DOI: 10.36229/978-65-5866-172-6.CAP.32
Capítulo 33: Edulcorantes: uma alternativa inteligente ou um vilão para a saúde
Caio Rodrigues de Oliveira, Maria da Conceição Tavares Cavalcanti Liberato
DOI: 10.36229/978-65-5866-172-6.CAP.33
Capítulo 34: Congelamento de hortaliças
Éven de Lima Paiva, Maria da Conceição Tavares Cavalcanti Liberato
DOI: 10.36229/978-65-5866-172-6.CAP.34
Capítulo 35: Fatores que afetam a qualidade de frutas e hortaliças durante a pós-colheita
Marília Sobral Souza, Maria da Conceição Tavares Cavalcanti Liberato
DOI: 10.36229/978-65-5866-172-6.CAP.35
Capítulo 36: Revisão bibliográfica sobre as propriedades fitoterápicas dos flavonoides
Alissa Ellen Queiroz Ribeiro Campos, Iaci Torres Paiva, Lumara Costa Rocha, Maria Da Conceição Tavares Cavalcanti Liberato
DOI: 10.36229/978-65-5866-172-6.CAP.36
Capítulo 37: Antocianinas: usadas como corantes alimentares e efeitos benéficos à saúde
Francisco Victor Saraiva de Sousa, Maria da Conceição Tavares Cavalcanti Liberato
DOI: 10.36229/978-65-5866-172-6.CAP.37
Capítulo 38: Microrganismos desejáveis
Lidia Pereira Lima, Sabrina de Oliveira Brito, Vanessa Sousa de Oliveira, Maria da Conceição Tavares Cavalcanti Liberato
DOI: 10.36229/978-65-5866-172-6.CAP.38
Capítulo 39: Rotulagem de alimentos
Francisco Antônio Severino Gomes, Maria da Conceição Tavares Cavalcanti Liberato
DOI: 10.36229/978-65-5866-172-6.CAP.39
Veja também esses outros títulos
Produtos relacionados
-

Práticas Agronômicas: eperiências da UNEMAT de Nova Mutum – Volume 2
Leia mais -

Gerenciamento regional de áreas contaminadas: avaliação de risco à saúde humana – Volume 2
Leia mais -

TÉCNICAS EM PAVIMENTAÇÃO RÍGIDA E FLEXÍVEL EM SUPERPAVE Seleção, Metodologia e Aplicação
Leia mais -

Gestão da Produção em Foco – Volume 48
Leia mais